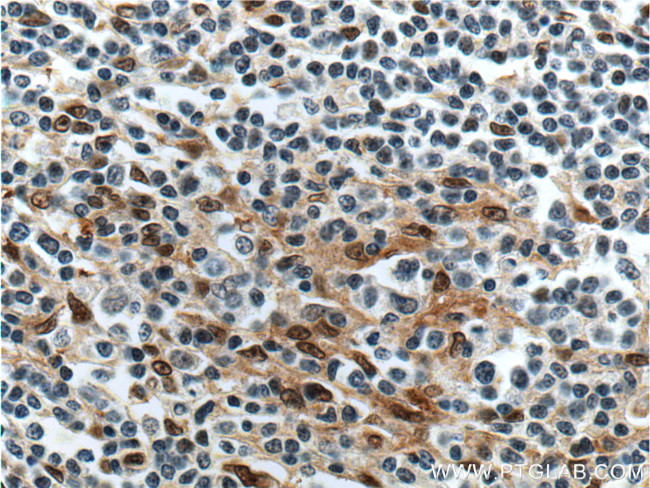
FLI1 Antibody in Immunohistochemistry (Paraffin) (IHC (P))

Search
Proteintech
FLI1 Polyclonal Antibody
{{$productOrderCtrl.translations['antibody.pdp.commerceCard.promotion.promotions']}}
{{$productOrderCtrl.translations['antibody.pdp.commerceCard.promotion.viewpromo']}}
{{$productOrderCtrl.translations['antibody.pdp.commerceCard.promotion.promocode']}}: {{promo.promoCode}} {{promo.promoTitle}} {{promo.promoDescription}}. {{$productOrderCtrl.translations['antibody.pdp.commerceCard.promotion.learnmore']}}
产品信息
11347-1-AP
种属反应
已发表种属
宿主/亚型
分类
类型
抗原
偶联物
形式
浓度
规格
纯化类型
保存液
内含物
保存条件
运输条件
产品详细信息
Immunogen sequence: NSYMDEKNG PPPPNMTTNE RRVIVPADPT LWTQEHVRQW LEWAIKEYSL MEIDTSFFQN MDGKELCKMN KEDFLRATTL YNTEVLLSHL SYLRESSLLA YNTTSHTDQS SRLSVKEDPS YDSVRRGAWG NNMNSGLNKS PPLGGAQTIS KNTEQRPQPD PYQILGPTSS RLANPGSGQI QLWQFLLELL SDSANASCIT WEGTNGEFKM TDPDEVARRW GERKSKPNMN YDKLSRALRY YYDKNIMTKV HGKRYAYKFD FHGIAQALQP HPTESSMYKY PSDISYMPSY HAHQQKVNFV PPHPSSMPVT SSSFFGAASQ YWTSPTGGIY PNPNVPRHPN THVPSHLGSY Y (103-452 aa encoded by BC010115)
靶标信息
The FLI1 (Friend Leukemia Integration 1) gene is located on chromosome 11q24.3 and belongs to the ETS (E26 transformation-specific) family of transcription factors. Structurally, FLI1 contains an ETS domain responsible for DNA binding and a pointed domain which facilitates protein-protein interactions. Functionally, it plays a critical role in the regulation of embryonic and hematopoietic development. It is also implicated in the pathogenesis of diseases such as Ewing's sarcoma, wherein a chromosomal translocation t(11;22)(q24;q12) forms the EWS-FLI1 fusion gene.
仅用于科研。不用于诊断过程。未经明确授权不得转售。
生物信息学
蛋白别名: alternate; ETS transcription factor; Ewing sarcoma breakpoint region 2; Friend leukemia integration 1; Friend leukemia integration 1 transcription factor; Friend leukemia virus integration 1; Proto-oncogene Fli-1; Retroviral integration site protein Fli-1; similar to FLI-1; Transcription factor ERGB; unnamed protein product
基因别名: BDPLT21; EWSR2; FLI-1; FLI1; SIC-1; Sic1
UniProt ID: (Human) Q01543, (Mouse) P26323
Entrez Gene ID: (Human) 2313, (Mouse) 14247